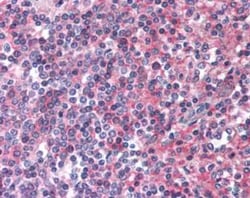
EMR2 Antibody - BSA Free, Novus Biologicals 0.05 mL, Unconjugated:Anticuerpos

missing translation for 'onlineSavingsMsg'
Learn More
Learn More
EMR2 Antibody - BSA Free, Novus Biologicals™
Rabbit Polyclonal Antibody
Marca: Novus Biologicals NLS1663
Este artículo no se puede devolver.
Vea la política de devoluciones
Descripción
EMR2 Polyclonal antibody specifically detects EMR2 in Human samples. It is validated for ELISA, Immunohistochemistry, Immunohistochemistry (Paraffin), Immunocytochemistry
Especificaciones
| EMR2 | |
| Polyclonal | |
| Unconjugated | |
| PBS | |
| Rabbit | |
| Immunogen affinity purified | |
| RUO | |
| Primary | |
| Human | |
| Purified |
| ELISA, Immunohistochemistry, Immunohistochemistry (Paraffin), Immunocytochemistry | |
| 1.0 mg/mL | |
| ELISA 1:100 - 1:2000, Immunohistochemistry, Immunohistochemistry-Paraffin 7.5 - 15 μg/mL, Immunocytochemistry 1:10 - 1:500 | |
| CD312, DKFZp781B135, egf-like module containing, mucin-like, hormone receptor-like 2, egf-like module containing, mucin-like, hormone receptor-like sequence 2, EGF-like module receptor 2, EGF-like module-containing mucin-like hormone receptor-like 2 | |
| Synthetic 20 amino acid peptide from N-terminal extracellular domain of human EMR2. | |
| 0.05 mL | |
| GPCR | |
| 30817 | |
| Keep as concentrated solution. Aliquot and store at -20°C or below. Avoid multiple freeze/thaw cycles. | |
| IgG |
Corrección del contenido de un producto
Proporcione sus comentarios sobre el contenido del producto rellenando el siguiente formulario.
Título del producto
Spot an opportunity for improvement?Share a Content Correction